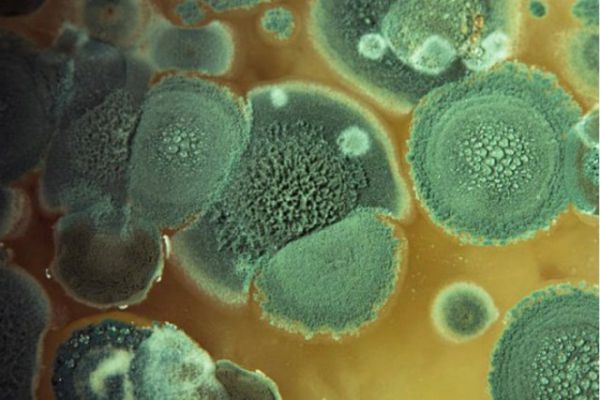

А вы видели хлеб с плесенью? Такую картину легко обнаружить у себя в хлебнице, да и в других местах. Стоит только кусочку хлеба немного полежать, как на нем легко и быстро расцветает плесень. Часто первые проявления плесени очень незаметны и такой хлеб может вполне пойти в пищу. Более того, многие, обнаружив на хлебе плесень, просто срезают пораженный кусочек, а все остальное пускают в дело.
Но это занятие весьма рискованное - споры плесени даже в небольшом количестве могут вызывать самые серьезные последствия со стороны здоровья. Если плесень попадает в тело человека с едой, то способность к размножению она теряет. Но главное оружие - миотоксин - остается при ней.
Даже в небольшом куске хлеба может оказаться достаточно миотоксина, чтобы привести к катастрофе. Самым малым стане отравление во всей его красе. Следующей может пострадать печень.
Если миотоксина поступает в организм много, то может начаться мутация клеток, что ведет за собой онкологические заболевания. Плесень может также спровоцировать сильнейший приступ аллергии, что потребует незамедлительного обращения к врачу. Но рот - не единственный путь проникновения плесени. Ее споры можно вдохнуть, в этом случае плесневые грибки будут иметь доступ к кислороду и прекрасную среду для размножения...
Так что увидев хотя бы малейшие признаки плесени на хлебе, лучше не рисковать. а как можно скорее отправить все в мусорное ведро.